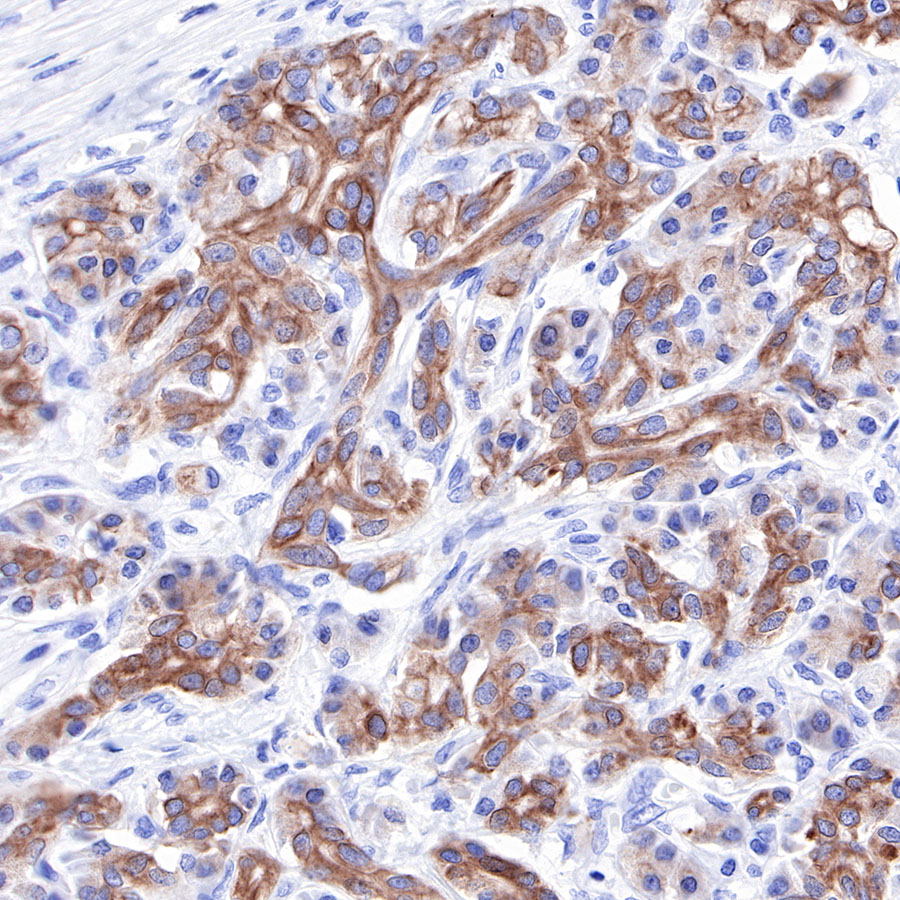

WB result of Keratin 18 Rabbit mAb
Primary antibody: Keratin 18 Rabbit mAb at 1/2500 dilution
Lane 1: HeLa whole cell lysate 20 µg
Lane 2: MCF7 whole cell lysate 20 µg
Secondary antibody: Goat Anti-Rabbit IgG, (H+L), HRP conjugated at 1/10000 dilution
Predicted MW: 46 kDa
Observed MW: 42 kDa
Exposure time: 120s
Product Details
Product Details
Product Specification
Host | Rabbit |
Antigen | Keratin 18 |
Synonyms | Cytokeratin-18, CK-18 |
Immunogen | N/A |
Location | Cytoplasm |
Accession | P05783 |
Clone Number | SDT-R081 |
Antibody Type | Rabbit mAb |
Application | WB, IHC-P, ICC |
Reactivity | Hu |
Purification | Protein A |
Concentration | 0.025 mg/ml |
Physical Appearance | Liquid |
Storage Buffer | PBS, 40% Glycerol, 0.05%BSA, 0.03% Proclin 300 |
Stability & Storage | 12 months from date of receipt / reconstitution, -20 °C as supplied |
Dilution
application | dilution | species |
WB | 1:2500 | |
IHC-P | 1:200-1:500 | |
ICC | 1:25 |
Background
Cytokeratins are proteins of cytoskeletal intermediate filaments, and their main function is to enable cells to withstand mechanical stress. In humans, 20 different cytokeratin isotypes have been identified. Cytokeratins 8, 18, 19, and 20 have been associated with bladder. Cytokeratin 18 (KRT18, also called K18), found in epithelial cells, is released from hepatocytes upon death.
Picture
Picture
Western Blot

Immunohistochemistry

IHC shows positive staining in paraffin-embedded human breast cancer. Anti-Keratin 18 antibody was used at 1/2000 dilution, followed by a HRP Polymer for Mouse & Rabbit IgG (ready to use). Counterstained with hematoxylin. Heat mediated antigen retrieval with Tris/EDTA buffer pH9.0 was performed before commencing with IHC staining protocol.

IHC shows positive staining in paraffin-embedded human colon cancer. Anti-Keratin 18 antibody was used at 1/2000 dilution, followed by a HRP Polymer for Mouse & Rabbit IgG (ready to use). Counterstained with hematoxylin. Heat mediated antigen retrieval with Tris/EDTA buffer pH9.0 was performed before commencing with IHC staining protocol.
IHC shows positive staining in paraffin-embedded human pancreatic carcinoma. Anti-Keratin 18 antibody was used at 1/2000 dilution, followed by a HRP Polymer for Mouse & Rabbit IgG (ready to use). Counterstained with hematoxylin. Heat mediated antigen retrieval with Tris/EDTA buffer pH9.0 was performed before commencing with IHC staining protocol.

IHC shows positive staining in paraffin-embedded human prostatic hyperplasia. Anti-Keratin 18 antibody was used at 1/2000 dilution, followed by a HRP Polymer for Mouse & Rabbit IgG (ready to use). Counterstained with hematoxylin. Heat mediated antigen retrieval with Tris/EDTA buffer pH9.0 was performed before commencing with IHC staining protocol.

Negative control: IHC shows negative staining in paraffin-embedded human cervical carcinoma. Anti-Keratin 18 antibody was used at 1/2000 dilution, followed by a HRP Polymer for Mouse & Rabbit IgG (ready to use). Counterstained with hematoxylin. Heat mediated antigen retrieval with Tris/EDTA buffer pH9.0 was performed before commencing with IHC staining protocol.

Negative control: IHC shows negative staining in paraffin-embedded human lung squamous cell carcinoma. Anti-Keratin 18 antibody was used at 1/2000 dilution, followed by a HRP Polymer for Mouse & Rabbit IgG (ready to use). Counterstained with hematoxylin. Heat mediated antigen retrieval with Tris/EDTA buffer pH9.0 was performed before commencing with IHC staining protocol.
Immunocytochemistry

ICC shows positive staining in MCF7 cells. Anti-Keratin 18 antibody was used at 1/25 dilution (Green) and incubated overnight at 4°C. Goat polyclonal Antibody to Rabbit IgG - H&L (Alexa Fluor® 488) was used as secondary antibody at 1/1000 dilution. The cells were fixed with 100% ice-cold methanol and permeabilized with 0.1% PBS-Triton X-100. Nuclei were counterstained with DAPI (Blue).Counterstain with tubulin (Red).







